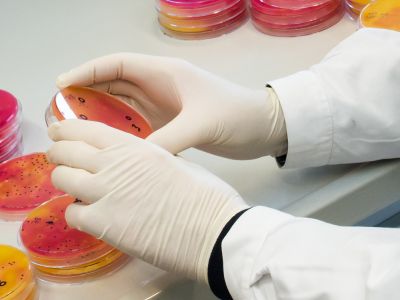
241 1

MIKROFLORA AM RINDFLEISCH - VON DER VERARBEITUNG BIS ZU LAGERUNG
Entschlüsselung von mikrobiellen Kontaminations- und Wachstumsszenarien unter verschiedenen Verarbeitungs- und Lagerungsbedingungen während der Rinderschlachtung zur Optimierung der Produktqualität
Foto: Michael Bernkopf (VETMEDUNI)

Foto: Thomas Suchanek (VETMEDUNI)

Foto: Thomas Suchanek (VETMEDUNI)
Die Vermeidung von Lebensmittelabfall ist für eine nachhaltige Lebensmittelproduktion unabdingbar. Jährlich landen ca. 1,3 Milliarden Tonnen Lebensmittel im Müll; das entspricht einem Drittel der globalen Lebensmittelproduktion. Der Verderb von Lebensmitteln durch die Mikroflora, die während der Verarbeitung oder Lagerung mit dem Produkt in Kontakt kommt, spielt dabei eine große Rolle. Mikrobielle Fleischkontamination und Rekontamination während der Schlachtung sind dabei besonders komplexe Ereignisse, die schwer zu überwachen sind. Viele Einflussfaktoren, einschließlich intrinsischer, extrinsischer, technologischer und impliziter Faktoren, tragen alle zur endgültigen Zusammensetzung der mikrobiellen Gemeinschaft eines Fleischprodukts bei. Menschliche und technische Eingriffe bei der Schlachtung, tierbezogene mikrobielle Muster, Reinigungs- und Desinfektionsroutinen, mehrfaches Einfrieren und unterschiedliche Lagerungstemperaturen, sowie stochastische Kontaminationsereignisse beeinflussen den mikrobiellen Austausch in einem Schlachthof. Auch wenn alle diese Schritte bestmöglich ausgeführt und kontrolliert werden, gibt es immer ein Risiko einer mikrobiellen Kontamination. Um ein mikrobiologisch sicheres Lebensmittel zu garantieren, ist es enorm wichtig, die kritischsten Verarbeitungsschritte und Lagerungsbedingungen zu identifizieren. In diesem Projekt wenden wir neben Standardmethoden auch innovative DNA-Sequenzierungstechnologien an, um eine mikrobielle Risikokarte zu erstellen, die mikrobielle Übertragungswege innerhalb der Einrichtung und mikrobielle Hotspots zeigt. In einem weiteren Schritt wird der Einfluss verschiedener Lagerungsbedingungen, Einfrierzyklen und der Einfluss verschiedener keimreduzierender Verfahren auf die Zusammensetzung der mikrobiellen Gemeinschaft auf dem Endprodukt untersucht.
Lead Researcher:
Ass.-Prof. Mag.med.vet. Evelyne Selberherr, PhD
Team Leiterin
Zentrum für Lebensmittelwissenschaften und Öffentliches Veterinärwesen, Abteilung für Lebensmittelmikrobiologie (Veterinärmedizinische Universität Wien)
evelyne.selberherr@vetmeduni.ac.at
+43 1 25077-3510
www.vetmeduni.ac.at
